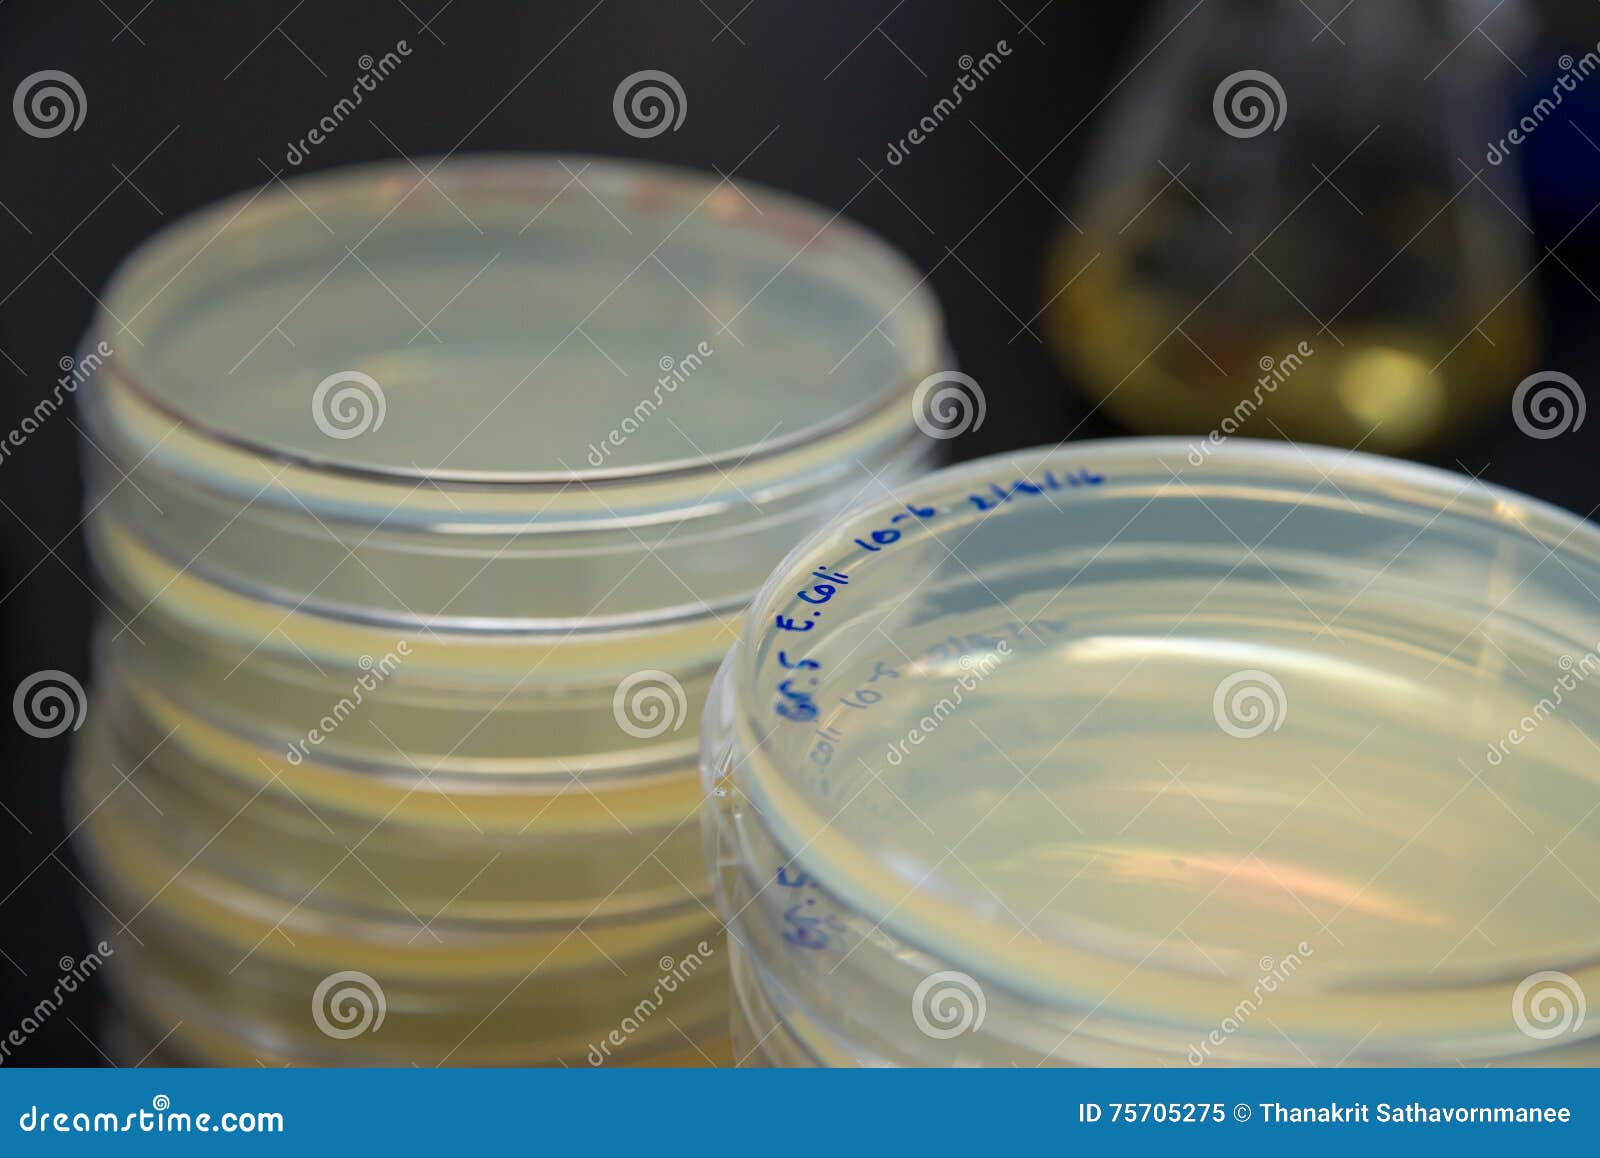
Colorazione Batterica In Microorganismi A Piastra Di Petri Piastre Di Petri Supporti Di Coltura Con Batteri Isolati Generative Ai 301673152

Condensatore Liebig In Vetro Borosilicato Stonylab
16 €IVA inclusa
Consegna
30 giorni per restituire il tuo ordine
Rivendi
Vetro Borosilicato Condensatore Liebig In Stonylab Sollevatore Moto Colonna Distillazione Condensatore A Colonna Laboy Vetro 200mm - Distillazione Vigreux, Con Lo risolveremo fino a quando soddisfatti. 200 mm nella lunghezza della giacca [Garanzia] Se ricevuti danneggiati, vi preghiamo di contattarci immediatamente. Realizzato in vetro di alta qualità; Temperatura massima di resistenza 200°C L’StonyLab Tech è rappresentato prodotti di alta qualità con prezzi ragionevoli. Le nostre custodie sono designate alla moda e stati prodotto con cura per la sicurezza della misura esatta per il funzionamento quotidiano del suo dispositivo Realizzato in vetro borosilicato di alta qualità, resiste fino a 200°C e ha una lunghezza di 200 mm. I giunti standard 24/40 in alto e in basso lo rendono...